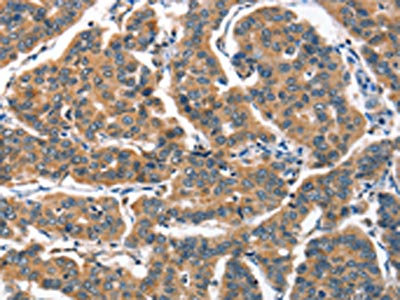

-
中文名稱:ALOX15兔多克隆抗體
-
貨號:CSB-PA624049
-
規格:¥1100
-
圖片:
-
The image on the left is immunohistochemistry of paraffin-embedded Human thyroid cancer tissue using CSB-PA624049(ALOX15 Antibody) at dilution 1/60, on the right is treated with synthetic peptide. (Original magnification: ×200)
-
The image on the left is immunohistochemistry of paraffin-embedded Human breast cancer tissue using CSB-PA624049(ALOX15 Antibody) at dilution 1/60, on the right is treated with synthetic peptide. (Original magnification: ×200)
-
Gel: 10%SDS-PAGE, Lysate: 40 μg, Lane: Hela cells, Primary antibody: CSB-PA624049(ALOX15 Antibody) at dilution 1/1300, Secondary antibody: Goat anti rabbit IgG at 1/8000 dilution, Exposure time: 1 minute
-
-
其他:
產品詳情
-
Uniprot No.:
-
基因名:
-
別名:15 lipoxygenase 1 antibody; 15 LIPOXYGENASE RETICULOCYTE ARACHIDONATE antibody; 15 LOX antibody; 15 LOX 1 antibody; 15-LOX antibody; 15LOX 1 antibody; ALOX15 antibody; Arachidonate 15 lipoxygenase antibody; Arachidonate 15-lipoxygenase antibody; Arachidonate omega 6 lipoxygenase antibody; Arachidonate omega-6 lipoxygenase antibody; LOG15 antibody; LOX15_HUMAN antibody
-
宿主:Rabbit
-
反應種屬:Human,Mouse,Rat
-
免疫原:Synthetic peptide of Human ALOX15
-
免疫原種屬:Homo sapiens (Human)
-
標記方式:Non-conjugated
-
抗體亞型:IgG
-
純化方式:Antigen affinity purification
-
濃度:It differs from different batches. Please contact us to confirm it.
-
保存緩沖液:-20°C, pH7.4 PBS, 0.05% NaN3, 40% Glycerol
-
產品提供形式:Liquid
-
應用范圍:ELISA,WB,IHC
-
推薦稀釋比:
Application Recommended Dilution ELISA 1:2000-1:10000 WB 1:1000-1:5000 IHC 1:50-1:200 -
Protocols:
-
儲存條件:Upon receipt, store at -20°C or -80°C. Avoid repeated freeze.
-
貨期:Basically, we can dispatch the products out in 1-3 working days after receiving your orders. Delivery time maybe differs from different purchasing way or location, please kindly consult your local distributors for specific delivery time.
-
用途:For Research Use Only. Not for use in diagnostic or therapeutic procedures.
引用文獻
- DEHP induces ferroptosis in testes via p38α-lipid ROS circulation and destroys the BTB integrity L Yang,Food and chemical toxicology,2023
相關產品
靶點詳情
-
功能:Non-heme iron-containing dioxygenase that catalyzes the stereo-specific peroxidation of free and esterified polyunsaturated fatty acids generating a spectrum of bioactive lipid mediators. It inserts peroxyl groups at C12 or C15 of arachidonate ((5Z,8Z,11Z,14Z)-eicosatetraenoate) producing both 12-hydroperoxyeicosatetraenoate/12-HPETE and 15-hydroperoxyeicosatetraenoate/15-HPETE. It may then act on 12-HPETE to produce hepoxilins, which may show proinflammatory properties. Can also peroxidize linoleate ((9Z,12Z)-octadecadienoate) to 13-hydroperoxyoctadecadienoate/13-HPODE. May participate in the sequential oxidations of DHA ((4Z,7Z,10Z,13Z,16Z,19Z)-docosahexaenoate) to generate specialized pro-resolving mediators (SPMs)like resolvin D5 ((7S,17S)-diHPDHA) and (7S,14S)-diHPDHA, that actively downregulate the immune response and have anti-aggregation properties with platelets. Can convert epoxy fatty acids to hydroperoxy-epoxides derivatives followed by an intramolecular nucleophilic substitution leading to the formation of monocyclic endoperoxides. Plays an important role during the maintenance of self-tolerance by peroxidizing membrane-bound phosphatidylethanolamine which can then signal the sorting process for clearance of apoptotic cells during inflammation and prevent an autoimmune response. In addition to its role in the immune and inflammatory responses, this enzyme may play a role in epithelial wound healing in the cornea through production of lipoxin A4 (LXA(4)) and docosahexaenoic acid-derived neuroprotectin D1 (NPD1; 10R,17S-HDHA), both lipid autacoids exhibit anti-inflammatory and neuroprotective properties. Furthermore, it may regulate actin polymerization which is crucial for several biological processes such as the phagocytosis of apoptotic cells. It is also implicated in the generation of endogenous ligands for peroxisome proliferator activated receptor (PPAR-gamma), hence modulating macrophage development and function. It may also exert a negative effect on skeletal development by regulating bone mass through this pathway. As well as participates in ER stress and downstream inflammation in adipocytes, pancreatic islets, and liver. Finally, it is also involved in the cellular response to IL13/interleukin-13.
-
基因功能參考文獻:
- Study in the dextran sulfate sodium colitis model utilizing transgenic mice overexpressing human ALOX15 suggests a pro-inflammatory activity of human 15-LOX1. PMID: 29702245
- Pinosylvin enhances the apoptosis of LPS preconditioned leukocytes by up-regulating ALOX 15 expression through ERK and JNK. PMID: 29555013
- indicate regulation of Alox15 mRNA expression in neuroblastoma cells by histone modifications, and increasing Alox15 expression in differentiating neurons PMID: 29235036
- The present study shows that rs7217186:C > T and rs2619112:G > A of ALOX15 are associated with increased risk of CAD in the North Indian population. PMID: 29068244
- Results identify ALOX15, which was upregulated under low oxygen conditions and is associated with an increase in the rate of phagocytosis of apoptotic cells. PMID: 28887380
- the results indicate that 15-LO-1 has an important role in the disease progression of osteoarthritis. Thus 15-LO-1 may be a good target for developing drugs in the treatment of osteoarthritis. PMID: 29022900
- 15-LOX-1 expression in colon and prostate cancer cells leads to reduced angiogenesis. These changes could be mediated by an increase in the expression of both ICAM-1 and the anti-angiogenic protein TSP-1. PMID: 28757355
- Polymorphisms in the ALOX15 gene may influence periodontal disease pathogenesis. Hence, investigation of such polymorphisms could benefit the evaluation of lipoxins role in periodontal disease PMID: 28492741
- Results suggest an evolution of ALOX15 (12/15-lipoxygenase)specificity. PMID: 27412860
- Compound heterozygous mutations in DYNC2H1 and ALOX15 were identified in miscarriages from two families with RPL. DYNC2H1 is involved in cilia biogenesis and has been associated with fetal lethality in humans. ALOX15 is expressed in placenta and its dysregulation has been associated with inflammation, placental, dysfunction, abnormal oxidative stress response and angiogenesis. PMID: 26826164
- Immunofluorescence analyses revealed that the ALOX15 protein consistently localizes to cell membrane during the course of ferroptosis. Importantly, treatments of cells with ALOX15-activating compounds accelerated cell death at low, but not high doses of erastin and RSL3 PMID: 28837253
- present in late-stage germ cells of the testis PMID: 28339608
- Studied human umbilical cord mesenchymal stem cell (hucMSCs) transplantation in DSS-induced inflammatory bowel disease (IBD); hucMSC transplantation significantly relieved IBD symptoms thru the regulation of 15-LOX-1 expression and modulation of inflammatory responses in macrophages. PMID: 28258529
- Findings suggest that 12/15-lipoxygenase (12/15-LO)-mediated enzymatic lipid oxidation serves as a key mechanism controlling eosinophil-directed coagulation and physiological hemostasis. PMID: 28566277
- These results indicated that 15-LOX-1 is a potential target for inhibiting the trafficking of DCs to lymphoid organs and inflamed tissues and decreasing the inflammatory response attenuating symptoms of certain immunologic and inflammatory disorders such as dermatitis. PMID: 27825104
- Kelavkar and Badr (1999) stated that the ALOX15 gene maps to 17p13.3 in close proximity to the tumor-suppressor gene TP53 and stated that the ALOX15 gene product is implicated in antiinflammation, membrane remodeling, and cancer development/metastasis. PMID: 10200270
- we propose that increased ALOX15 expression in heart tissue under ischemic conditions may lead to increased production of 15-HETE, potentially contributing to thrombosis. PMID: 27552229
- the results of the present study indicated that the natural products, CA, quercetin and morin hydrate, offer potential as adjuvant therapeutic agents for SMinduced toxicity, not only by reducing inflammation mediated by the p38 and LOX signaling pathways, but also by decreasing the generation of ROS and nitrate/nitrite. PMID: 27665716
- 15-LOX-1 re-expression downregulates the expression of MTA1 in colorectal cancer cell lines. PMID: 27320813
- The molecular origin of substrate specificity of 15-LOX-1 for linoleic acid in comparison with arachidonic acid has been analyzed. PMID: 26646740
- Hypoxia increase the production of ROS through the 15-Lipoxygenase/15-Hydroxyeicosatetraenoiccid pathway. PMID: 26871724
- The role of 15-LOX-1 in colitis and colitis-associated colorectal cancer PMID: 26194111
- variation in inflammation related genes ALOX15 and IL6 was associated with bone microarchitecture and density in young adult women, but appears to be less important in the elderly PMID: 26036173
- Significant associations with NSAID-exacerbated respiratory disease were identified for: ALOX15 homozygous genotype and PTGS-1 rs5789 A/A homozygous genotype PMID: 26067486
- limiting ALOX15 expression by AMPK may promote an anti-inflammatory phenotype of IL-4-stimulated human macrophages PMID: 26276392
- Effect of 12/15-LOX on colorectal tumorigenesis in mouse models could be affected by tumor cell type (human or mouse), relative 12/15 LOX activity in tumor cells and stroma as well as the relative tumor 13-HODE and 12-HETE levels. PMID: 25576922
- enzymatic activity and the intracellular membrane-binding function of 15-LO1 appear to contribute to HIF-1alpha suppression PMID: 24668884
- These findings demonstrate that 15-LOX-1 expression loss in cancer cells promotes metastasis and that therapeutically targeting ubiquitous 15-LOX-1 loss in cancer cells has the potential to suppress metastasis. PMID: 24634093
- Loss of Alox15 altered expression of PTEN, PI3K/AKT, and the transcription factor ICSBP PMID: 25105362
- ALOX 12 may have a critical role in regulation of inflammation in visceral adipose tissue in obesity and type 2 diabetes. PMID: 24955608
- results demonstrate that UTX is implicated in IL-4 mediated transcriptional activation of the ALOX15 gene PMID: 24465480
- Positive ALOX15 expression is more prevalent in eosinophilic esophagitis than in gastroesophageal reflux disease PMID: 24742828
- h15-LO-1-derived metabolites are highly vasoactive and may play a critical role in regulating coronary blood flow PMID: 23872364
- The results of our study failed to confirm whether the selected variants in ALOX15 gene within the LT metabolism pathway contribute to platelet reactivity in a diabetic population treated with ASA. PMID: 23828562
- Our data support a role for 12/15-LOX activation as an inflammatory mediator of injury in periventricular leukomalacia PMID: 23838566
- Data indicate a strong negative correlation between ALOX15, FADS2, and IL5RA expression with 2-arachidonoylglycerophosphocholine levels in dual asthmatic responses. PMID: 23844124
- COX-2 promotes while 15-LOX-1 inhibits colonic tumorigenesis (Review). PMID: 22960430
- The conserved glycine is of functional importance for ALOX15 enzyme variants; most mutants at this position lose catalytic activity. PMID: 23958500
- In transgenic knock-out 12/15-LOX mice, there is a reduction in dopamine striatal levels following neurotoxicant challenge compared to wild-type. PMID: 23079635
- Evidence suggests that up-regulation of 15-LO in vascular endothelium results in increased synthesis of arachidonic acid metabolites, increased membrane hyperpolarization, and enhanced contribution to relaxation by endothelial agonists. [REVIEW] PMID: 23249676
- histone methylation/demethylation at the 15-LOX-1 promoter is important in the transcriptional regulation of the gene in cultured cells. PMID: 23285160
- Genetic variant may play a role in NSAID induced acute urticaria. PMID: 23181793
- The rs7217186 and rs2619112 polymorphisms of the ALOX15 gene are associated with ischemic stroke in males and in patients with atherosclerosis in northern Chinese Han population. PMID: 22351111
- findings demonstrate that 15-LOX-1-mediated metabolism of DHA is required for it to upregulate SDC-1 and trigger the signaling pathway that elicits apoptosis in prostate cancer cells PMID: 23066085
- This study suggests that vimentin binds the ALOX15 promoter and regulates its promoter activity and protein expression PMID: 22879973
- promoter polymorphisms of the ALOX15 gene affect ALOX15 activity leading to increased eosinophil infiltration in aspirin-exacerbated respiratory disease PMID: 22652554
- Mice with human 15-LOX-1 expression in colonic epithelial cells were less susceptible than wild-type mice to AOM-induced colonic tumorigenesis. 15-LOX-1 appears to act as a tumor suppressor and an inhibitor of TNF-alpha-iNOS signaling and NF-kappaB activation. PMID: 22472308
- increased ALOX15 in human ischemic heart biopsies was demonstrated. PMID: 22750246
- Results support the pro-apoptotic role of 15-lipoxygenase-1 and suggest that 15-lipoxygenase-1 could be a potential new target gene for the therapy of malignant glioma. PMID: 22210710
- rs916055 in ALOX15 gene was significantly associated with the percentage of fat mass in Chinese nuclear families with male offspring in the family-based association study using quantitative transmission disequilibrium test approach. PMID: 22301860
顯示更多
收起更多
-
相關疾病:Disease susceptibility may be associated with variations affecting the gene represented in this entry. Met at position 560 may confer interindividual susceptibility to coronary artery disease (CAD) (PubMed:17959182).
-
亞細胞定位:Cytoplasm, cytosol. Cell membrane; Peripheral membrane protein. Lipid droplet.
-
蛋白家族:Lipoxygenase family
-
組織特異性:Detected in monocytes and eosinophils (at protein level). Expressed in airway epithelial cells.
-
數據庫鏈接:
Most popular with customers
-
-
YWHAB Recombinant Monoclonal Antibody
Applications: ELISA, WB, IHC, IF, FC
Species Reactivity: Human, Mouse, Rat
-
Phospho-YAP1 (S127) Recombinant Monoclonal Antibody
Applications: ELISA, WB, IHC
Species Reactivity: Human
-
-
-
-
-